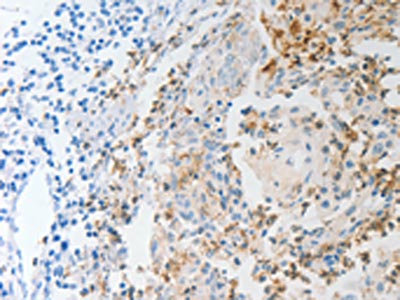

-
中文名稱:NFKB2兔多克隆抗體
-
貨號:CSB-PA785439
-
規格:¥1100
-
圖片:
-
其他:
產品詳情
-
Uniprot No.:
-
基因名:
-
別名:CVID10 antibody; DNA binding factor KBF2 antibody; DNA-binding factor KBF2 antibody; H2TF1 antibody; Lymphocyte translocation chromosome 10 antibody; Lymphocyte translocation chromosome 10 protein antibody; Lyt 10 antibody; Lyt10 antibody; NF kB2 antibody; NFKB2 antibody; NFKB2_HUMAN antibody; Nuclear factor NF kappa B p100 subunit antibody; Nuclear factor NF kappa B p52 subunit antibody; Nuclear factor NF-kappa-B p52 subunit antibody; Nuclear factor of kappa light chain gene enhancer in B cells 2 antibody; Nuclear factor of kappa light polypeptide gene enhancer in B cells 2 antibody; Nuclear factor of kappa light polypeptide gene enhancer in B-cells 2 antibody; Oncogene Lyt 10 antibody; Oncogene Lyt-10 antibody; p105 antibody; p49/p100 antibody
-
宿主:Rabbit
-
反應種屬:Human,Mouse
-
免疫原:Synthetic peptide of Human NFKB2
-
免疫原種屬:Homo sapiens (Human)
-
標記方式:Non-conjugated
-
抗體亞型:IgG
-
純化方式:Antigen affinity purification
-
濃度:It differs from different batches. Please contact us to confirm it.
-
保存緩沖液:-20°C, pH7.4 PBS, 0.05% NaN3, 40% Glycerol
-
產品提供形式:Liquid
-
應用范圍:ELISA,IHC
-
推薦稀釋比:
Application Recommended Dilution ELISA 1:1000-1:2000 IHC 1:15-1:50 -
Protocols:
-
儲存條件:Upon receipt, store at -20°C or -80°C. Avoid repeated freeze.
-
貨期:Basically, we can dispatch the products out in 1-3 working days after receiving your orders. Delivery time maybe differs from different purchasing way or location, please kindly consult your local distributors for specific delivery time.
-
用途:For Research Use Only. Not for use in diagnostic or therapeutic procedures.
相關產品
靶點詳情
-
功能:NF-kappa-B is a pleiotropic transcription factor present in almost all cell types and is the endpoint of a series of signal transduction events that are initiated by a vast array of stimuli related to many biological processes such as inflammation, immunity, differentiation, cell growth, tumorigenesis and apoptosis. NF-kappa-B is a homo- or heterodimeric complex formed by the Rel-like domain-containing proteins RELA/p65, RELB, NFKB1/p105, NFKB1/p50, REL and NFKB2/p52. The dimers bind at kappa-B sites in the DNA of their target genes and the individual dimers have distinct preferences for different kappa-B sites that they can bind with distinguishable affinity and specificity. Different dimer combinations act as transcriptional activators or repressors, respectively. NF-kappa-B is controlled by various mechanisms of post-translational modification and subcellular compartmentalization as well as by interactions with other cofactors or corepressors. NF-kappa-B complexes are held in the cytoplasm in an inactive state complexed with members of the NF-kappa-B inhibitor (I-kappa-B) family. In a conventional activation pathway, I-kappa-B is phosphorylated by I-kappa-B kinases (IKKs) in response to different activators, subsequently degraded thus liberating the active NF-kappa-B complex which translocates to the nucleus. In a non-canonical activation pathway, the MAP3K14-activated CHUK/IKKA homodimer phosphorylates NFKB2/p100 associated with RelB, inducing its proteolytic processing to NFKB2/p52 and the formation of NF-kappa-B RelB-p52 complexes. The NF-kappa-B heterodimeric RelB-p52 complex is a transcriptional activator. The NF-kappa-B p52-p52 homodimer is a transcriptional repressor. NFKB2 appears to have dual functions such as cytoplasmic retention of attached NF-kappa-B proteins by p100 and generation of p52 by a cotranslational processing. The proteasome-mediated process ensures the production of both p52 and p100 and preserves their independent function. p52 binds to the kappa-B consensus sequence 5'-GGRNNYYCC-3', located in the enhancer region of genes involved in immune response and acute phase reactions. p52 and p100 are respectively the minor and major form; the processing of p100 being relatively poor. Isoform p49 is a subunit of the NF-kappa-B protein complex, which stimulates the HIV enhancer in synergy with p65. In concert with RELB, regulates the circadian clock by repressing the transcriptional activator activity of the CLOCK-ARNTL/BMAL1 heterodimer.
-
基因功能參考文獻:
- Functional evaluation of natural killer cell cytotoxic activity in NFKB2-mutated patients. PMID: 29278687
- the present study demonstrated that NFKB2 may be involved in the development of HL by interacting with several genes and miRNAs, including BCL2L1, CSF2, miR-135a-5p, miR-155-5p and miR-9-5p. PMID: 29693141
- TNF-alpha-induced expression of transport protein genes in HUVEC cells is associated with enhanced expression of RELB and NFKB2. PMID: 29658079
- This study demonstrated that NF-kappaB mRNA levels were significantly decreased in the new cases of untreated MS patients in comparison to healthy controls. PMID: 28433998
- our studies for the first time establish p100 as a key tumor suppressor of bladder cancer growth PMID: 27095572
- results suggest that changes in the relative concentrations of RelB, NIK:IKK1, and p100 during noncanonical signaling modulate this transitional complex and are critical for maintaining the fine balance between the processing and protection of p100. PMID: 27678221
- report a detailed state-of-the-art mass spectrometry-based protein-protein interaction network including the noncanonical NF-kappaB signaling nodes TRAF2, TRAF3, IKKalpha, NIK, and NF-kappaB2/p100. PMID: 27416764
- novel NFKB2 gain-of-function mutations produce a nonfully penetrant combined immunodeficiency phenotype through a different pathophysiologic mechanism than previously described for mutations in NFKB2 PMID: 28778864
- a new ERK2/AP-1/miR-494/PTEN pathway that is responsible for the tumor-suppressive role of NFkappaB2 p100 in cellular transformation. PMID: 26686085
- MKK4 activates non-canonical NFkappaB signaling by promoting NFkappaB2-p100 processing. PMID: 28733031
- the aberrant proliferative capacity of Brca1(-/-) luminal progenitor cells is linked to the replication-associated DNA damage response, where proliferation of mammary progenitors is perpetuated by damage-induced, autologous NF-kappaB signaling. PMID: 27292187
- RelB is processed by CO2 in a manner dependent on a key C-terminal domain located in its transactivation domain. Loss of the RelB transactivation domain alters NF-kappaB-dependent transcriptional activity, and loss of p100 alters sensitivity of RelB to CO2 PMID: 28507099
- Thyroidal NF-kappaB2 (noncanonical) activity is more pronounced in Graves disease than in normal thyroids. PMID: 27929668
- Gene expression levels of NF-kappaB2 were deregulated in 49 B-cell chronic lymphocytic leukemia, 8 B-cell non-Hodgkin's lymphoma, 3 acute myeloid leukemia, 3 chronic myeloid leukemia, 2 hairy cell leukemia, 2 myelodysplastic syndrome, and 2 T-cell large granular lymphocytic leukemia patients in the post-Chernobyl period. PMID: 25912249
- melatonin transcriptionally inhibited MMP-9 by reducing p65- and p52-DNA-binding activities. Moreover, the Akt-mediated JNK1/2 and ERK1/2 signaling pathways were involved in melatonin-regulated MMP-9 transactivation and cell motility. PMID: 26732239
- results suggest that glucocorticoids induce a transcription complex consisting of RelB/p52, CBP, and HDAC1 that triggers a dynamic acetylation-mediated epigenetic change to induce CRH expression in full-term human placenta. PMID: 26307012
- HDAC4-RelB-p52 complex maintains repressive chromatin around proapoptotic genes Bim and BMF and regulates multiple myeloma survival and growth PMID: 26455434
- The augmentation of methylation in the NFkB2 promoter by interval walking training is advantageous in promoting a healthy state by ameliorating the susceptibility to inflammation PMID: 25901949
- Data show that NF-kappa-B p52 subunit (p52) interacts with ets transcription factors ETS1/2 factors at the C250T telomerase (TERT) promoter to mediate TERT reactivation. PMID: 26389665
- mutation results in common variable immunodeficiency with reduction in B cells, memory B cells and T follicular helper cells PMID: 24888602
- Results confirm previous findings that de novo mutations near the C-terminus of NFKB2 cause combined endocrine and immunodeficiencies. PMID: 25524009
- The unique ability of p100/IkappaBdelta to stably interact with all NF-kappaB subunits by forming kappaBsomes demonstrates its importance in sequestering NF-kappaB subunits and releasing them as dictated by specific stimuli for developmental programs. PMID: 25349408
- NIK plays a key role in constitutive NF-kappaB activation and the progression of ovarian cancer cells PMID: 24533079
- We report 3 related individuals with a novel form of severe B-cell deficiency associated with partial persistence of serum immunoglobulin arising from a missense mutation in NFKB2. PMID: 25237204
- NFkappaB2/p100 was overexpressed and accumulated in a well-established in vitro human monocyte model of Endotoxin tolerance. The p100 accumulation in these cells inversely correlated with the inflammatory response after LPS stimulation. PMID: 25225662
- NFKB2 genetic variation associated with sleep disorders in patients, diagnosed with breast cancer. PMID: 24012192
- higher level of expression is associated with death in non-small cell lung cancer PMID: 24355259
- NF-kappaB2/p100 deficiency caused a predominant B-cell-intrinsic TI-2 defect that could largely be attributed to impaired proliferation of plasmablasts. Importantly, p100 was also necessary for efficient defense against clinically relevant TI-2 pathogens. PMID: 24242887
- NFKB2 binds to the PLK4 promoter at upstream and downstream of the PLK4 transcription initiation site abd reduced PLK4 mRNA and protein levels. PMID: 23974100
- our study demonstrates a link between persistent activation of the AR by NF-kappaB2/p52 and development of resistance to enzalutamide in prostate cancer. PMID: 23699654
- Single nucleotide polymorphisms of angiotensin-converting enzyme (ACE), nuclear factor kappa B (NFkB)and cholesteryl ester transport protein (CETP) were evaluated in nonagenarians, centenarians, and average life span individuals (controls). PMID: 23389097
- Heterozygous mutations in NFKB2 cause a unique form of early-onset CVID that also presents with central adrenal insufficiency. PMID: 24140114
- Constitutive processing of C-terminal truncation mutants of p100 is associated with their active nuclear translocation. Mutation of the nuclear localization signal (NLS) of p100 abolishes its processing. PMID: 12894228
- Sp1 is required for IL-15 induction by both poly(I:C) and respiratory syncytial virus, a response that also requires NFkappaB2 and IKKepsilon. PMID: 23873932
- TRAF2/NIK/NF-kappaB2 pathway regulates pancreatic ductal adenocarcinoma cell tumorigenicity PMID: 23301098
- the FBXW7alpha-dependent degradation of p100 functions as a prosurvival mechanism through control of NF-kappaB activity. PMID: 23211527
- These findings provide a mouse model for human multiple myeloma with aberrant NF-kappaB2 activation and suggest a molecular mechanism for NF-kappaB2 signaling in the pathogenesis of plasma cell tumors. PMID: 22642622
- RelB/NF-kappaB2, is constitutively activated in the human placenta, which binds to a previously undescribed NF-kappaB enhancer of corticotropin-releasing hormone (CRH) gene promoter to regulate CRH expression. PMID: 22734038
- The noncanonical NF-kappaB pathway is integral in controlling immunoregulatory phenotypes of both plasmacytoid and conventional dendritic cells. PMID: 22879398
- Fbw7-mediated destruction of p100 is a regulatory component restricting the response to NF-kappaB2 pathway stimulation. PMID: 22864569
- Flt3ITD promotes a noncanonical pathway via TAK1 and p52NF-kappaB to suppress DAPK1 in association with histone deacetylases, which explains DAPK1 repression in Flt3ITD(+) acute myeloid leukemia. PMID: 22096027
- NF-kappaB2 exhibits the major inhibitory role in the transcription at the CD99 promoter PMID: 22083306
- mutant p53 elevates expression of genes capable of enhancing cell proliferation, motility, and tumorigenicity by inducing acetylation of histones via recruitment of CBP and STAT2 on the promoters causing CBP-mediated histone acetylation PMID: 22198284
- Total expression of nuclear factor kappa B-2 was not significantly changed in melphalan resistance in multiple myeloma, but more of the protein population was converted into the p52 isoform PMID: 21846842
- The activation profile of diffuse large B-cell lymphomas/posttransplantation lymphoproliferative disorders was not associated with BAFF/BAFF-R expression, whereas nuclear p52 activation might be linked to Epstein-Barr virus. PMID: 21871426
- Data show that IKBalpha, NFKB2, and TRAF3 gene polymorphisms play a role in the development of multiple myeloma and in the response to bortezomib therapy. PMID: 21228035
- Data show that MEKK-1 plays an integral role in IL-1beta modulation of Caco-2 TJ barrier function by regulating the activation of the canonical NF-kappaB pathway and the MLCK gene. PMID: 21048223
- Role of NFKB2 on the early myeloid differentiation of CD34+ hematopoietic stem/progenitor cells PMID: 20708837
- NF-kappaB2/p52 may play a critical role in the progression of castration-resistant prostate cancer through activation of the androgen receptor PMID: 20388792
- Data demonstrate in various tumor cell lines and primary T-cells that TNFR2, but not TNFR1, induces activation of the alternative NFkappaB pathway and p100 processing. PMID: 20038584
顯示更多
收起更多
-
相關疾病:Immunodeficiency, common variable, 10 (CVID10)
-
亞細胞定位:Nucleus. Cytoplasm. Note=Nuclear, but also found in the cytoplasm in an inactive form complexed to an inhibitor (I-kappa-B).
-
數據庫鏈接:
Most popular with customers
-
-
YWHAB Recombinant Monoclonal Antibody
Applications: ELISA, WB, IHC, IF, FC
Species Reactivity: Human, Mouse, Rat
-
Phospho-YAP1 (S127) Recombinant Monoclonal Antibody
Applications: ELISA, WB, IHC
Species Reactivity: Human
-
-
-
-
-